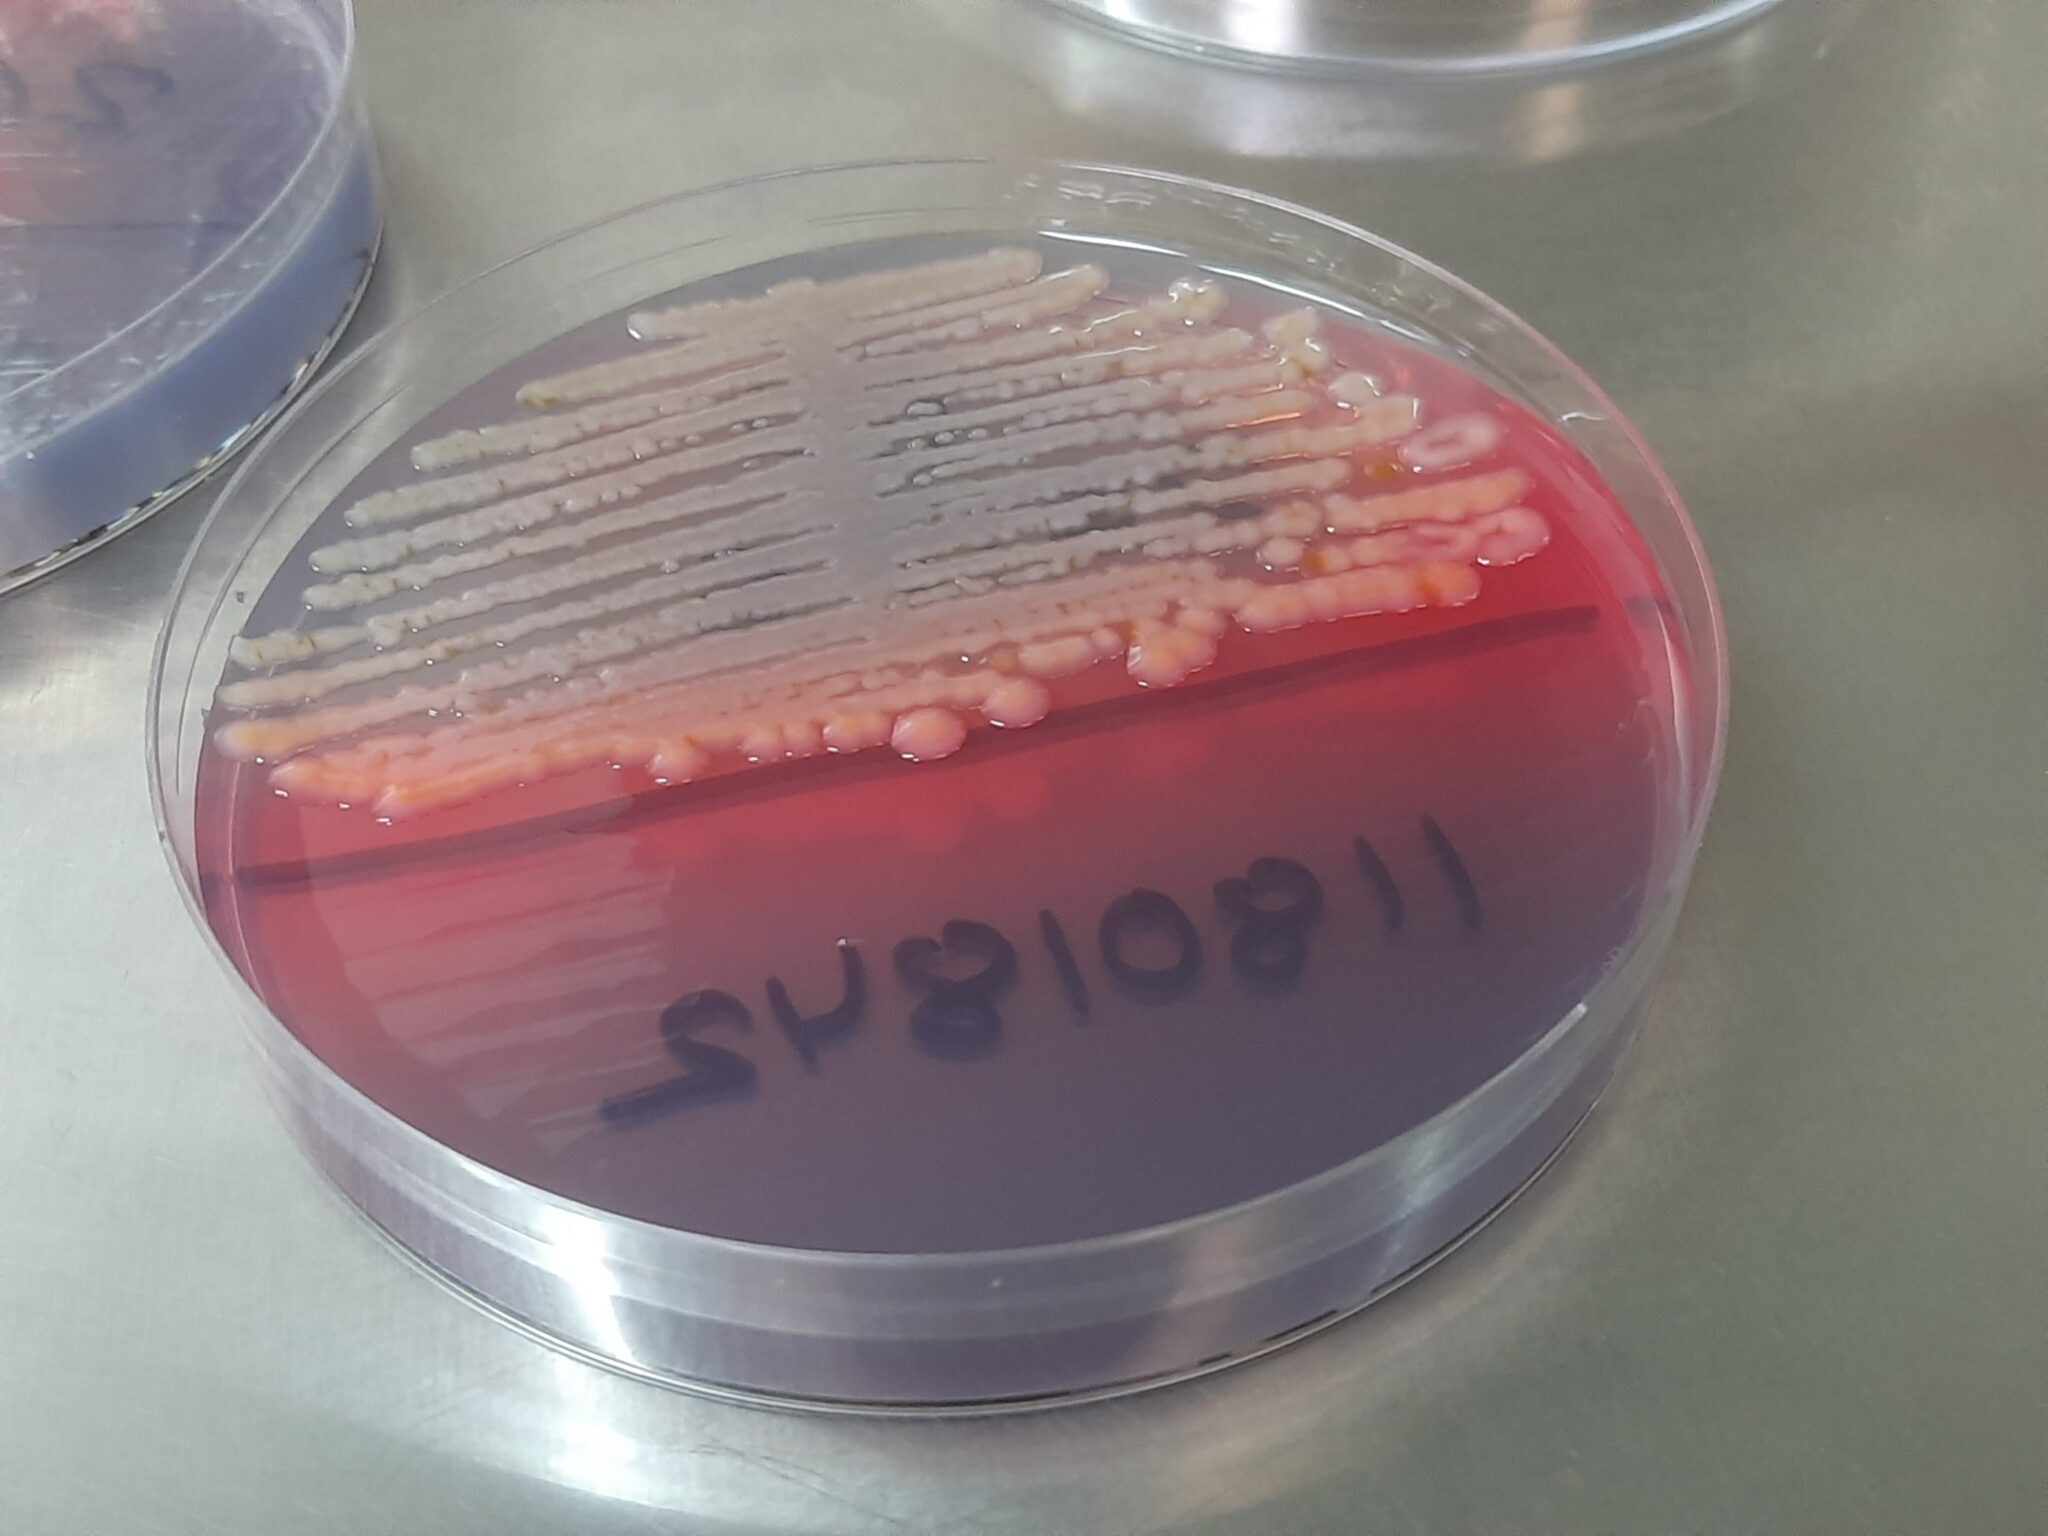

En décembre 2025, la Commission européenne a présenté un projet de loi qui assouplirait considérablement les règles de protection actuelles applicables aux micro-organismes génétiquement modifiés (MGM). Les bactéries et autres micro-organismes modifiés à l’aide des nouvelles techniques de génie génétique (NTGG) pourraient à l’avenir être disséminés dans l’environnement plus rapidement et sous des conditions moins strictes – par exemple sous forme d’engrais, de produits phytosanitaires ou d’additifs alimentaires destinés à réduire les émissions de méthane chez les ruminants. Aux États-Unis, ces bactéries sont déjà pulvérisées sur les champs. L’objectif du projet est de réduire les obstacles bureaucratiques – les obligations actuelles en matière d’évaluation et de contrôle seraient ainsi largement supprimées.
Dissémination facilitée et nouvelles catégories
Jusqu’à présent, la dissémination de MGM dans l’environnement était considérée comme trop risquée, car ils peuvent rapidement échanger leur patrimoine génétique entre eux et ne peuvent être récupérés en cas de problème. C’est pourquoi ils n’étaient utilisés que dans des systèmes fermés (fermenteurs) – même si, dans ce cas, . Le projet prévoit toutefois de classer certains micro-organismes comme « à faible risque ». Pour cela, il suffit que l’espèce de l’organisme soit bien décrite scientifiquement, qu’elle ne contienne pas de gènes préoccupants tels que des gènes de résistance aux antibiotiques et qu’elle soit classée comme « probablement sûre » par l’Autorité européenne de sécurité des aliments (EFSA) ( Statut QPS ). Le QPS est une procédure visant à simplifier l’évaluation de la sécurité, utilisée jusqu’à présent dans la production alimentaire. La liste QPS est constamment enrichie et comprend actuellement plus de 120 micro-organismes, ce qui représente un nombre très important. Pour ceux-ci, la Commission peut définir elle-même les exigences relatives aux documents à fournir et à l’évaluation des risques. Il est possible de renoncer à la surveillance a posteriori si le demandeur le souhaite.
Pour ces organismes, les procédures d’autorisation devraient être simplifiées et les obligations de traçabilité partiellement levées. De plus, les autorisations accordées pourraient être valables pour une durée illimitée, de sorte que les micro-organismes pourraient rester dans les sols et les écosystèmes pendant de nombreuses années. Ces modifications affaibliraient considérablement les normes de protection actuelles de la directive européenne 2001/18 sur la dissémination. Celle-ci exige une évaluation des risques et un étiquetage, et l’autorisation est limitée dans le temps. L’assouplissement prévu rendrait également le contrôle par les autorités beaucoup plus difficile.
Exemples et risques
La bactérie du sol Klebsiella variicola, qui fixe l’azote de l’air, constitue un exemple concret de la déréglementation envisagée. Grâce au génie génétique, elle est désormais censée libérer une partie de cet azote sous forme d’ammonium pour les plantes, réduisant ainsi l’utilisation d’engrais chimiques. Même si la Klebsiella génétiquement modifiée est considérée comme inoffensive aux États-Unis ou au Brésil, des risques considérables subsistent : Ces bactéries peuvent acquérir les propriétés de leurs cousines pathogènes – comme l’agent pathogène hautement infectieux Klebsiella pneumoniae – ou transmettre leurs gènes à d’autres micro-organismes par transfert génétique horizontal . Les conséquences à long terme pour l’écologie des sols, les plantes, les animaux et l’ensemble de l’écosystème ont jusqu’à présent été très peu étudiées.
De plus, la classification de l’EFSA ne couvre pas tous les aspects liés aux risques : elle ne tient pas compte, par exemple, des risques liés à la manipulation, tels que le contact cutané, l’inhalation ou l’ingestion, ni des éventuelles réactions allergiques. Les risques environnementaux liés aux OGM, notamment lorsqu’ils sont utilisés comme produits phytosanitaires, ne sont pas du tout évalués.
Klebsiella variicola n’a certes pas encore le statut QPS, mais cela ne devrait pas tarder. En effet, selon une étude de l’EFSA, la bactérie serait inoffensive dans les cultures céréalières – un transfert dans la chaîne alimentaire humaine et animale serait négligeable.
Critiques et conséquences
Les experts mettent en garde contre le fait que ce projet porte atteinte au principe de précaution et à la transparence. Les mesures jusqu’ici requises, telles qu’une évaluation minutieuse des risques, la surveillance et l’étiquetage des micro-organismes génétiquement modifiés, devraient être fortement réduites ou devenir facultatives. De plus, de nombreux détails de la réglementation ne seront fixés qu’ultérieurement dans ce qu’on appelle des actes délégués, ce qui limite le contrôle parlementaire. Sans obligations suffisantes en matière de documentation et de contrôle, il sera pratiquement impossible de savoir quels micro-organismes sont effectivement disséminés dans les sols. Le danger pour l’environnement est bien plus grand que dans le cas des plantes génétiquement modifiées, ont averti des experts de l’Agence fédérale autrichienne pour l’environnement et de l’Office fédéral allemand pour la protection de la nature dans une étude publiée en mars 2025.
Perspectives
L’ampleur de la simplification des exigences reste à déterminer – la Commission européenne ne fournira les documents relatifs à l’évaluation des risques allégée que dans des actes délégués. Le projet sera toutefois d’abord renvoyé au Parlement européen et au Conseil des ministres de l’UE pour qu’une position commune soit trouvée. La Commission insistera pour que les délibérations soient rapides. Son argument : la promotion de l’innovation et la compétitivité de l’industrie des OGM. C’est pourquoi elle renonce même à une analyse d’impact sur les conséquences possibles de la proposition de loi. À la place, seule une analyse coûts-bénéfices devrait suffire. Pour l’Alliance suisse pour une agriculture sans OGM, cela est inacceptable. Une telle déréglementation comporte des risques considérables pour les écosystèmes, pour l’agriculture sans OGM et pour la santé. De plus, il ne serait pas possible de garantir la liberté de choix.